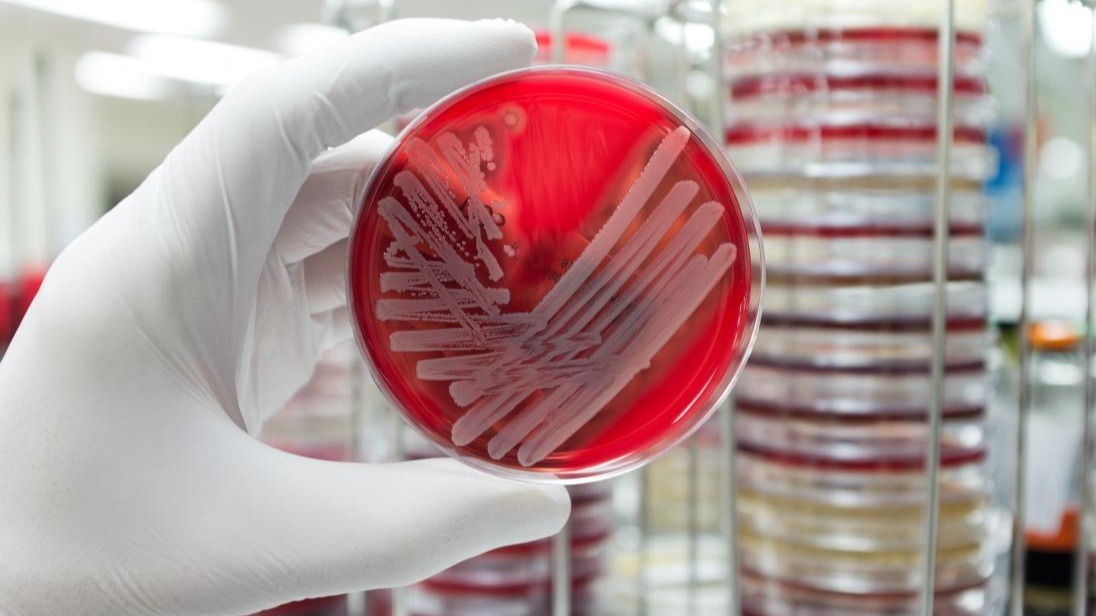
Antibiotic Resistance,  unique antibiotics, bacterial cellular, pill, microbiology

Breakthrough In Opposition To Antibiotic Resistance.
Hospitals, specifically areas such as intensive care gadgets and surgical wards, are teeming with bacteria, some of that is resistant to antibiotics they're infamously referred to as 'superbugs'.Superbug infections are hard and high priced to treat, and may frequently cause dire consequences for the
A primary chance of being hospitalized is catching a bacterial infection.
Hospitals, specifically areas such as intensive care gadgets and surgical wards, are teeming with bacteria, some of that is resistant to antibiotics they're infamously referred to as 'superbugs'.
Superbug infections are hard and high priced to treat, and may frequently cause dire consequences for the affected person. Now, new studies posted these days inside the magazine nature microbiology has discovered a way to revert antibiotic-resistance in one of the riskiest superbugs.
The approach includes the usage of bacteriophages (also called 'phages'). "phages are viruses, however, they cannot damage human beings," said lead study creator dr Fernando Gordillo Altamirano, from the Monash college of biological sciences.
"they only kill microorganisms." The study group investigated phages that can kill the world's leading superbug, Acinetobacter baumannii, which is accountable for up to 20 in line with cent of infections in-depth care gadgets.
"we've got a big panel of phages which can be capable of kill antibiotic-resistant a. Baumannii," said Dr. Jeremy Barr, senior creator of the observe and organization leader on the college of biological sciences and a part of the center to effect amr.
"however this superbug is sensible, and in an equal manner it becomes resistant to antibiotics, it also speedy will become immune to our phages," Dr. Barr said. The study pinpoints how the superbug becomes resistant to assault from phages, and in doing so, the superbug loses its resistance to antibiotics.
"a. Baumannii produces a pill, a viscous and sticky outer layer that protects it and stops the access of antibiotics," stated dr Gordillo Altamirano.
"our phages use that equal pill as their port of entry to infect the bacterial cellular. "with a purpose to escape from the phages, a. Baumannii stops producing its capsule; and that's when we will hit it with the antibiotics it used to face up to."
The examination showed resensitization to at least seven unique antibiotics. "this greatly expands the resources to deal with a. Baumannii infections," Dr. Barr said. "We are making this superbug plenty less scary." Even though extra studies are needed before this therapeutic approach may be carried out in the hospital, the possibilities are encouraging.
"The phages had tremendous results in experiments the use of mice, so we're excited to keep running on this method," stated dr Gordillo Altamirano. "we are showing that phages and antibiotics can work first-rate as a crew."
Disclaimer: The opinions expressed within this article are the personal opinions of the author. The facts and opinions appearing in the article do not reflect the views of 25hrNews and 25hrNews does not assume any responsibility or liability for the same.

(+91) 8081113111
(+91) 8081113111 pr@25hrnews.com
pr@25hrnews.com
